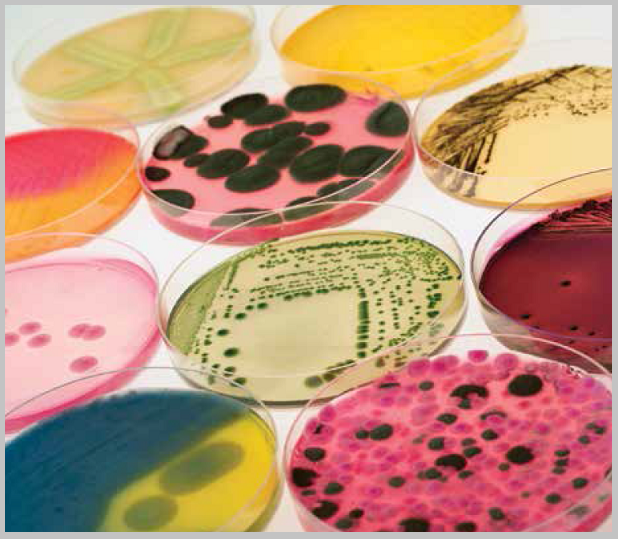

36.02.03 Зоотехния

Курс разработан для специальности 36.02.03. Зоотехния
36.02.03
- Преподаватель: Савченко Татьяна Юрьевна
36.02.03
- Преподаватель: Козина Елена Александровна

36.02.03

для 36.02.03
36.02.03
- Преподаватель: Агейкин Артем Геннадьевич

36.02.03
Содержание дисциплины охватывает круг вопросов, связанных с морфологией и физиологией микроорганизмов, экологией микроорганизмов, а так же вопросов санитарно-гигиенических требований к сельскохозяйственным объектам, кормам и системам обеспечения, затрагивает вопросы дезинфекции, дезинсекции и дератизации.

Для обучающихся по направлению подготовки:
36.02.03 Зоотехния СПО 11 класс
1 курс ИПБиВМ, очная форма обучения
Автор-составитель: Волкова Алла Григорьевна
Кафедра "Иностранных языков и профессиональных коммуникаций"
ИАЭТ

Для обучающихся по направлению подготовки:
36.02.03 Зоотехния СПО 9 класс
2 курс ИПБиВМ, очная форма обучения
Автор-составитель: Волкова Алла Григорьевна
Кафедра "Иностранных языков и профессиональных коммуникаций"
ИАЭТ

Для обучающихся по направлению подготовки:
36.02.03 Зоотехния СПО 9 класс
1 курс ИПБиВМ, очная форма обучения
Автор-составитель: Волкова Алла Григорьевна
Кафедра "Иностранных языков и профессиональных коммуникаций"
ИАЭТ
- Преподаватель: Лухтина Марина Анатольевна

для студентов СПО специальности 36.02.03 «Зоотехния»

